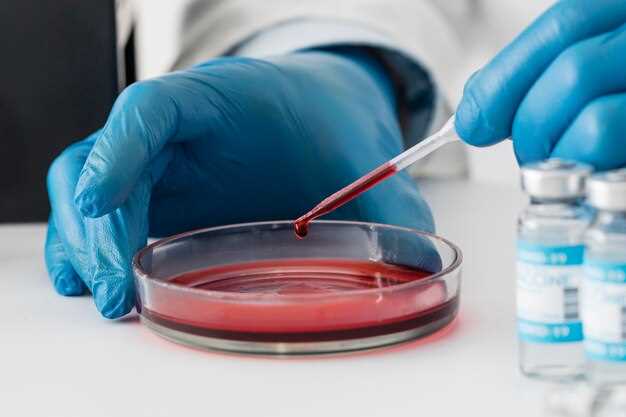
Importance of Atorvastatin

Atorvastatin chiral analysis
2026-02-07Looking for accurate and reliable chiral analysis for Atorvastatin?
Look no further! Our team of experienced scientists specialize in providing high-quality chiral analysis for Atorvastatin and other pharmaceutical compounds.
Why choose our Atorvastatin chiral analysis services?
1. Precision: Our state-of-the-art equipment and advanced methodologies ensure precise and accurate results.
2. Expertise: With years of experience in the field, our team of scientists is well-versed in chiral analysis techniques for Atorvastatin.
3. Fast Turnaround: We value your time, and our efficient processes allow us to deliver results quickly without compromising quality.
4. Comprehensive Reports: Our detailed reports provide you with all the necessary information you need for your research and development processes.
5. Confidentiality: We understand the importance of protecting your data and ensure utmost confidentiality throughout the analysis process.
Whether you are conducting research, developing pharmaceutical formulations, or seeking regulatory compliance, our Atorvastatin chiral analysis services can meet all your needs.
Contact us today to discuss your requirements and benefit from our reliable chiral analysis services!
Understanding chiral analysis
In order to fully comprehend the importance and impact of Atorvastatin, it is essential to have a clear understanding of chiral analysis. Chiral analysis is a technique used to determine the composition and properties of chiral molecules, which are compounds that exist as mirror-image isomers.
Chirality is a fundamental concept in chemistry, as it refers to the three-dimensional arrangement of atoms within a molecule. Chiral molecules are characterized by having a "handedness," with two non-superimposable mirror images known as enantiomers.
Atorvastatin, being a chiral molecule, exists as two enantiomers: (R)-atorvastatin and (S)-atorvastatin. The difference between these enantiomers lies in their spatial arrangement, making them biologically distinct from each other.
Understanding the chiral analysis of Atorvastatin is crucial because it allows researchers to accurately determine the concentration and purity of each enantiomer in a pharmaceutical product. This information is vital for ensuring the safety and efficacy of the medication, as the biological activity of each enantiomer may vary significantly.
Chiral analysis of Atorvastatin involves the use of advanced analytical techniques such as liquid chromatography coupled with mass spectrometry (LC-MS). This method allows for the separation and quantification of the (R)- and (S)-enantiomers, enabling researchers to monitor the potency and quality of the drug.
By comprehending chiral analysis, scientists and pharmaceutical companies can better evaluate the pharmacological effects and therapeutic potential of Atorvastatin. This knowledge ultimately contributes to the development of safer and more effective pharmaceutical formulations, benefiting patients worldwide.
| Understanding chiral analysis |
|---|
| Chirality and enantiomers |
| Importance of chiral analysis in Atorvastatin |
| Chiral analysis techniques |
| Benefits of accurate chiral analysis |
| Application in drug development |
Importance of Atorvastatin
Atorvastatin, a medication commonly known by its brand name Lipitor, plays a crucial role in cardiovascular health. As a member of the statin drug class, Atorvastatin is prescribed to help lower cholesterol levels and reduce the risk of heart attack, stroke, and other cardiovascular problems.
High cholesterol is a leading cause of heart disease and a major risk factor for developing life-threatening conditions. Atorvastatin works by inhibiting an enzyme called HMG-CoA reductase, which is responsible for producing cholesterol in the liver. By reducing cholesterol production, Atorvastatin helps to lower LDL (bad cholesterol) levels and increase HDL (good cholesterol) levels in the blood.
By effectively managing cholesterol levels, Atorvastatin helps to prevent the build-up of plaque in the arteries, reduce inflammation, and improve blood flow. This can significantly lower the risk of cardiovascular events like heart attacks and strokes.
Considering the global prevalence of cardiovascular diseases, the importance of Atorvastatin in managing these conditions cannot be overstated. Millions of people worldwide rely on Atorvastatin to keep their cholesterol levels in check and protect their heart health.
The role of Atorvastatin in cardiovascular health
Atorvastatin, a powerful cholesterol-lowering medication, plays a crucial role in maintaining cardiovascular health. High levels of cholesterol in the blood can lead to the formation of plaque in the arteries, resulting in atherosclerosis, or the hardening and narrowing of the arteries. This condition significantly increases the risk of heart attacks, strokes, and other cardiovascular diseases.
By inhibiting the enzyme HMG-CoA reductase, Atorvastatin helps reduce the production of cholesterol in the liver. This leads to a decrease in LDL cholesterol levels, commonly known as "bad" cholesterol. Atorvastatin also increases the levels of HDL cholesterol, often referred to as "good" cholesterol. By promoting the balance of cholesterol in the body, Atorvastatin can help prevent the buildup of plaque in the arteries, thus reducing the risk of cardiovascular diseases.
In addition to its cholesterol-lowering effects, Atorvastatin also possesses anti-inflammatory properties. Chronic inflammation is often associated with the development and progression of atherosclerosis. By reducing inflammation in the arteries, Atorvastatin can further contribute to maintaining cardiovascular health.
It is important to note that Atorvastatin is most effective when combined with a healthy lifestyle, including a balanced diet and regular exercise. By adopting these lifestyle changes alongside Atorvastatin treatment, individuals can significantly improve their cardiovascular health and reduce their risk of heart disease.
However, in order to ensure the effectiveness and safety of Atorvastatin treatment, accurate chiral analysis is crucial. Chiral analysis is the process of distinguishing between enantiomers, which are mirror-image forms of a molecule. Atorvastatin consists of two chiral centers, meaning it exists as four different stereoisomers. Identifying and quantifying these stereoisomers accurately is essential, as they may have distinct pharmacological activities and can vary in terms of efficacy and side effects.
Challenges in chiral analysis of Atorvastatin arise due to the complex nature of the molecule and the need for high precision. These challenges include the separation and characterization of the different stereoisomers, as well as the determination of their concentration in a given sample.
Accurate chiral analysis of Atorvastatin provides several benefits. It allows researchers and healthcare professionals to determine the exact composition of the medication, ensuring consistent quality and effectiveness. By understanding the individual stereoisomers, scientists can gain insights into their specific interactions with the body and their impact on cardiovascular health. This knowledge can help in the development of improved formulations and dosage regimens to maximize therapeutic benefits and minimize potential side effects.
With our innovative solution for chiral analysis of Atorvastatin, we aim to overcome these challenges and provide accurate and reliable results. By utilizing advanced analytical techniques, we can confidently identify and quantify the different stereoisomers, ensuring the safety and efficacy of Atorvastatin treatment. Together, with our innovative solution and your commitment to cardiovascular health, we can make strides towards a healthier future.
Challenges in chiral analysis of Atorvastatin
Chiral analysis of Atorvastatin presents various challenges due to its molecular structure and properties. Atorvastatin is a chiral compound, meaning it exists in two mirror-image forms known as enantiomers. These enantiomers have the same chemical formula but differ in their three-dimensional arrangement, resulting in distinct pharmacological activities.
One of the major challenges in chiral analysis of Atorvastatin is the need to accurately distinguish and quantify the individual enantiomers. The presence of both enantiomers in a drug can have different effects on the body, including differences in efficacy and side effects. Therefore, it is crucial to determine the ratios and concentrations of each enantiomer in pharmaceutical formulations.
Another challenge is the development of reliable analytical methods for chiral separation. Traditional chromatographic techniques often struggle to separate enantiomers efficiently, as they have very similar physical and chemical properties. Advanced techniques, such as high-performance liquid chromatography (HPLC) and supercritical fluid chromatography (SFC), are now being used to overcome these challenges and achieve accurate chiral separation.
Importance of accurate chiral analysis
Accurate chiral analysis of Atorvastatin is essential for several reasons. Firstly, it ensures the quality control of pharmaceutical products containing Atorvastatin, as it allows for the determination of the correct enantiomeric purity. This ensures that patients receive the intended therapeutic effects of the drug.
Secondly, accurate chiral analysis can help understand the pharmacokinetics and pharmacodynamics of Atorvastatin. By quantifying the concentrations of each enantiomer in the body, researchers can better understand how the drug is metabolized and how it interacts with target proteins. This knowledge can lead to the development of more effective and safer therapies.
In summary, the challenges in chiral analysis of Atorvastatin are overcome through advanced analytical techniques, allowing for accurate determination of enantiomeric ratios. Accurate chiral analysis is crucial for ensuring the quality and efficacy of Atorvastatin-based pharmaceuticals, as well as advancing our understanding of the drug's pharmacological properties.
Distinguishing between enantiomers
Distinguishing between these enantiomers is important because they can have different pharmacological activities and toxicities. For example, studies have shown that the R-Atorvastatin enantiomer is responsible for the cholesterol-lowering effects, while the S-Atorvastatin enantiomer is inactive.
Accurate chiral analysis is necessary to determine the presence and concentration of each enantiomer in a sample. This analysis involves separating the enantiomers using techniques such as high-performance liquid chromatography (HPLC) or gas chromatography (GC), and then quantifying their concentrations.
The importance of accurate chiral analysis
Accurate chiral analysis allows researchers and pharmaceutical companies to understand the pharmacological properties of each enantiomer and develop drugs that contain only the active enantiomer. This can lead to improved drug effectiveness and safety.
By distinguishing between enantiomers and determining their concentrations, scientists can optimize drug dosages and minimize unwanted side effects. Additionally, accurate chiral analysis ensures the quality control of drug formulations and helps to comply with regulatory guidelines.
| Benefits of accurate chiral analysis: |
|---|
| - Enables the development of safer and more effective drugs |
| - Improves drug dosing and reduces adverse effects |
| - Enhances quality control in the pharmaceutical industry |
| - Supports compliance with regulatory requirements |
Overall, accurate chiral analysis plays a crucial role in the pharmaceutical industry by allowing researchers to understand the properties of enantiomers, develop better drugs, and ensure the safety and efficacy of medications.
Benefits of accurate chiral analysis
Accurate chiral analysis of Atorvastatin offers several benefits in terms of drug effectiveness and safety. By determining the exact composition of the different enantiomers of Atorvastatin, pharmaceutical companies and researchers can better understand the mechanisms of action and potential side effects of the medication.
One of the main advantages of accurate chiral analysis is the ability to determine the optimal dosage for individual patients. Since different enantiomers may have different pharmacokinetic properties, knowing their exact composition can help healthcare professionals personalize the dosage and improve the therapeutic outcomes. This can lead to better treatment results and reduce the risk of adverse effects.
Accurate chiral analysis also plays a crucial role in ensuring the quality and consistency of pharmaceutical products. By identifying and quantifying the enantiomers present in different batches of Atorvastatin, manufacturers can guarantee that the medication meets the required standards and specifications. This can help avoid variations in drug potency and bioavailability, ensuring that patients receive a reliable and consistent product.
Improved understanding of drug interactions
An accurate chiral analysis of Atorvastatin can provide valuable insights into potential drug interactions. Since enantiomers may interact with other drugs or substances differently, understanding their behavior can help identify possible interactions that can alter the medication's efficacy or increase the risk of side effects. This information can assist healthcare providers in making informed decisions about prescribing Atorvastatin in combination with other medications.
Enhanced drug development and research
Chiral analysis is essential in the development of new drugs and researching the effects of Atorvastatin. By accurately characterizing the enantiomers and understanding their individual properties, researchers can design more effective and safer drugs. This knowledge can aid in the optimization of drug formulations, dosage regimens, and delivery systems, leading to improved therapeutic options for patients.
| Benefits of accurate chiral analysis: |
|---|
| Personalized dosing |
| Ensuring product quality and consistency |
| Improved understanding of drug interactions |
| Enhanced drug development and research |
Improving drug effectiveness and safety
Determining the correct enantiomer of Atorvastatin is crucial for ensuring the maximum effectiveness and safety of the drug. By accurately analyzing the chiral properties of Atorvastatin, we can identify the specific enantiomer that possesses the desired pharmacological activity, and eliminate any potential adverse effects that may be caused by the other enantiomer. This is especially important in the case of Atorvastatin, as both enantiomers can exhibit different properties and potencies.
With our innovative chiral analysis solution, we can provide accurate and reliable identification of the enantiomers in Atorvastatin. This allows for precise characterization of the drug and ensures that patients receive the most appropriate and effective treatment.
By improving the chiral analysis of Atorvastatin, we can also contribute to overall patient safety. Ensuring that the drug is free from any impurities or unwanted enantiomers can help prevent potential side effects and minimize the risk of adverse reactions. This is particularly important for patients with pre-existing medical conditions or who are taking other medications.
| Benefits of our chiral analysis: |
| • Enhanced drug effectiveness |
| • Improved patient safety |
| • Precise characterization of drug properties |
| • Minimized risk of adverse reactions |
| • Tailored treatment for individual patients |
Atorvastatin plays a vital role in cardiovascular health, and our chiral analysis solution ensures that patients receive the most appropriate and safe treatment. Trust our innovative approach to improve drug effectiveness and safety.
Our innovative solution
Atorvastatin chiral analysis poses several challenges due to the presence of multiple enantiomers. However, our company has developed an innovative solution that simplifies and improves the accuracy of chiral analysis for Atorvastatin.
Advanced technology
We utilize state-of-the-art chiral analysis techniques, including high-performance liquid chromatography (HPLC) and mass spectrometry (MS), to accurately identify and quantify the different enantiomers of Atorvastatin. Our advanced technology allows for precise and reliable results.
Streamlined process
With our innovative solution, the process of chiral analysis for Atorvastatin is streamlined and efficient. Our expert team has optimized the sample preparation and analysis techniques, reducing the time and resources required for the analysis.
Using our solution, researchers and pharmaceutical companies can save valuable time and resources while obtaining accurate and reliable chiral analysis results for Atorvastatin. This helps in speeding up the drug development process and ensures the effectiveness and safety of Atorvastatin.
| Benefits of our solution: |
|---|
| - Accurate identification and quantification of Atorvastatin enantiomers |
| - Streamlined and efficient chiral analysis process |
| - Savings in time and resources for researchers and pharmaceutical companies |
| - Ensures the effectiveness and safety of Atorvastatin |